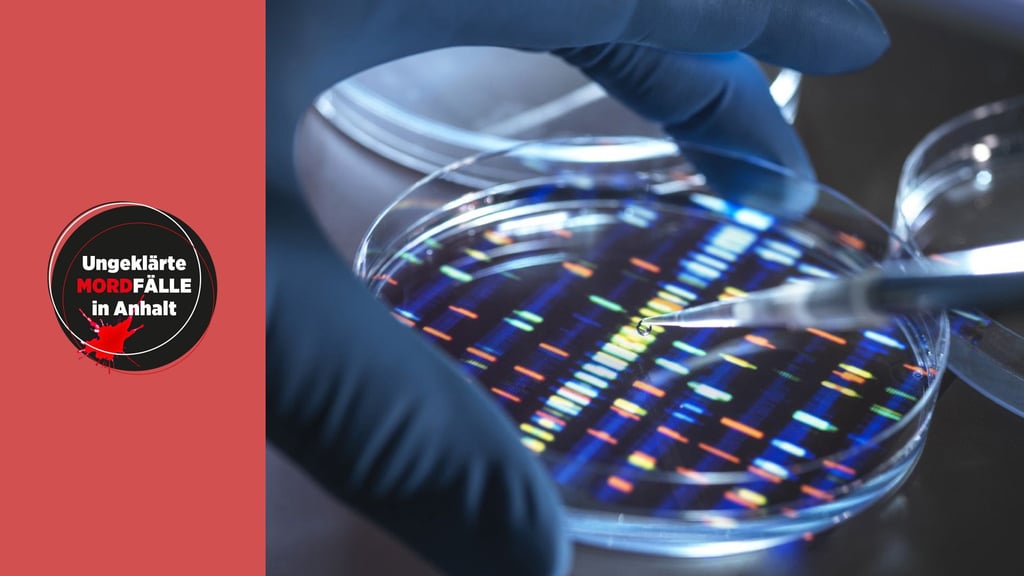
Welche Relevanz haben DNA-Spuren in der Mord-Ermittlung?

MZ-Serie - Ungesühnte Gewaltverbrechen Ungeklärte Mordfälle: Diese Fälle aus Anhalt konnte die Polizei seit 1989 nicht aufklären
Fünf Fälle haben Redakteure der MZ und der Volksstimme noch einmal näher beleuchtet und mit Kriminal-Experten gesprochen.

Dessau/MZ - Elf ungeklärte Mordfälle gibt es im Bereich der Polizeiinspektion Dessau seit der Wende. Diese Zahl wurde auf MZ-Anfrage genannt. Eine Recherche darüber ist kompliziert. Vom Stillinge-Mord (2015) und dem Toten aus der Kiste bei Vockerode (2016) abgesehen, liegen alle 20 Jahre und mehr Jahre zurück. Mord verjährt zwar nicht - allerdings gibt es kaum Hoffnung, dass die alten Fälle noch aufgeklärt werden. Sie gelten als ausermittelt. Dass die Akten immer mal wieder nach neuen Ansätzen durchsucht werden, entspricht wohl eher der Fantasie von Tatort-Drehbuch-Autoren - oder von Journalisten.
Fünf Fälle haben Redakteure der MZ und der Volksstimme noch einmal näher beleuchtet und mit Kriminal-Experten gesprochen. Alle Teile sind als MZ-Plus-Serie bereits jetzt im Internet auf www.mz.de zu finden. In der gedruckten Ausgabe erscheinen die Fälle in den nächsten Wochen.
Teil 1 - Mord in der Pension in Roßlau
Der Täter wurde nie gefasst. Gibt es einen Zusammenhang mit einem zweiten Verbrechen zwei Tage später?
Teil 2 - Der Tote aus der Kiste
Vor sechs Jahren wird zwischen den Anschlussstellen Coswig und Vockerode am Elbufer eine Metallkiste mit einer Leiche entdeckt. Aber wer ist der Tote? Bis heute rätseln die Ermittler.
Teil 3 - Silvana O. - Verbrannt in Zerbst
Vor 30 Jahren verschwand Silvana O. in Zerbst. Ihre verkohlte Leiche wurde wenig später auf dem ehemaligen Schießplatz der sowjetischen Armee gefunden. Der Mord ist bis heute ungeklärt.
Die 17-jährige Schülerin verschwand 1990 auf dem Weg mit dem Zug in ihr Internat in Wiesenburg. Erst Monate später ist ihre Leiche gefunden worden. Ein Tatverdächtiger ist 2003 verstorben.
Teil 5 - Hinrichtung in den Stillingen
Kurz vor Weihnachten muss die Feuerwehr einen brennenden Ford im Tiergarten löschen. Mit diesem Wagen war Drogendealer Rene Anton unterwegs.
DNA-Spuren können helfen, Verbrechen aufzuklären. 1988 wurde damit in Deutschland das erste Mal ein Täter überführt. Wie Experten des Rechtsmedizinischen Instituts in Halle vorgehen.
Teil 7 - „Cold Cases“: Was schafft die OFA?
Die Aufklärungsquote bei Mordfällen ist außergewöhnlich hoch. Weil Täter oft aus dem engeren Umfeld des Opfers stammen. Warum es trotzdem immer wieder „Cold Cases“, kalte Fälle, gibt.
Zu einigen weiteren Fällen sind die Informationen rar
Im Februar 1993 wurde ein Mann tot in seinem Wohnhaus in Oranienbaum gefunden. Das Opfer wies Anzeichen stumpfer Gewalt sowie Schussverletzungen auf. Die Täter wurden nie gefasst.
Im Mai 1994 wurde ein Mann in einem Waldgebiet zwischen Oranienbaum und Vockerode entdeckt - erschossen. Der Mann wurde zuvor in Leipzig als vermisst gemeldet. Das Fahrzeug des Vermissten war im Juli 1993 ausgebrannt in Hessen gefunden worden.
Ebenfalls 1994 wurde ein Mann vor dem Gehweg seiner Wohnung in der Dessauer Taubenstraße erschossen - um 1.16 Uhr in der Nacht, beim Rauchen einer Zigarette. Der 28-Jährige soll Verbindungen in die Schutzgeldszene gehabt haben.
Im Oktober 1996 stoßen Pilzsammler zwischen Bone und Bornum bei Zerbst auf einen Toten. Bei der Tatortarbeit wird eine zweite Leiche entdeckt. Die beiden Vietnamesen konnten nie identifiziert werden.
Ein Radfahrer entdeckt im November 1998 in Dessau-Süd einen Toten. Es ist ein Obdachloser. Der 43-Jährige wurde durch fünf Schläge an den Kopf getötet.
Im August 2001 wurde eine Invalidenrentnerin tot in ihrer Plattenbauwohnung in der Bobbauer Straße in Wolfen-Nord gefunden. Eine Obduktion ergab, dass die Frau erwürgt wurde. Sie wohnte in einem fast leer stehenden Eingang. Obwohl 150 Leute im Umfeld befragt werden, gibt es keinen Ansatz. 2003 werden die Ermittlungen eingestellt.